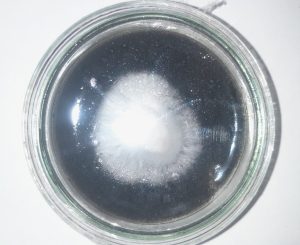
Pleurotus Ostreatus strain M2191 cultured on a mix MEA with 15% SCG pellets

In 2025 research was undertaken at Coed Talylan to evaluate pelletised spent coffee grounds (SCG) as a substrate for growing oyster mushrooms. The work was carried out as part of a wider effort to develop low‑impact, locally sourced substrates and circular resource flows for small‑scale mushroom cultivation in Wales.
 Rationale
Rationale
- Coffee grounds are produced in large volumes across the UK and are typically treated as waste.
- They are nitrogen‑rich and partially lignocellulosic
- Pelletising the grounds stabilises them, reduces moisture content, improves storage, and creates a consistent input for substrate blending.
- Developing a locally produced SCG-based pellet couldutilise this significant waste stream.
- Integrating this with existing horticultural and woodland restoration work creates a closed-loop model where spent substrate becomes a feedstock for peat‑free compost.
What We Did
- Trialled SCG pellets produced by
- Conducted test cultivations with Pleurotus ostreatus using blocks
- Compared pure SCG pellets with different blended ratios of straw pellets
- Evaluated colonisation rates, contamination frequency, fruiting yield, structural integrity, and moisture dynamics of each blend.
- Assessed the quality and potential horticultural value of the spent substrate.
 Key Findings
Key Findings
- SCG alone are too dense and nutrient‑rich, leading to overheating and increased contamination when used as the sole substrate.
- Blending with straw pellets significantly improves aeration, contributed to faster colonisation and lower contamination rates
- Yields were highest in blends containing 50% and 75 % SCG to straw pellets
- 100% SCG blocks took longer to colonise but were denser providing greater structure which allowed for subsequent flushes beyond the 2 flushes on the test
- The spent substrate showed promising qualities for use as a peat‑free compost feedstock, crumbly, carbon rich and nutrient deplete.
Opportunities Identified
- Developing a custom pellet blend
- Current pellets are pure SCG. A blended pellet could combine SCG with straw, sawdust, or other agricultural by‑products with targeted amendments of calcium carbonate and calcium sulfate.
- Pelletising the blend would create a uniform, shelf‑stable, low‑cost substrate input.
- Scaling regional SCG collection
- A coordinated collection route would support cafés, reduce waste disposal, and secure a steady input.
- Integration with compost production
- Spent mushroom substrate derived from SCG blends can serve as a base for peat‑free compost.
- This aligns with active sphagnum moss trials and broader peat‑replacement work at Coed Talylan.
- Local supply chain development
- Creating a Wales‑based sustainable substrate industry reduces reliance on imported materials.
- Applied mycology education and training
- The project provides a practical case study for courses and outreach programmes.
Next Steps
Next Steps
- Design and run a second controlled trial focused on:
- Determining optimum SCG:straw ratios.
- Testing additions of sawdust and other lignocellulosic inputs.
- Evaluating performance across multiple Pleurotus strains.
- Measuring yield, contamination, energy efficiency, and labour inputs.
- Prototype a blended pellet using pelletising equipment.
- Establish partnerships with coffee shops, cafés, and roasters for reliable SCG supply.
- Develop the spent substrate into a peat‑free compost product in conjunction with the sphagnum cultivation trials.
- Seek funding for a dedicated processing unit to support pellet production, substrate blending, and composting.
Conclusion
The initial SCG pellet trials have shown that coffee grounds can play a central role in creating a regional, circular substrate system for mushroom production in Wales. With further refinement, blended SCG pellets could underpin a low‑impact, scalable substrate that supports both mushroom growers and peat‑free compost development. This provides a strong foundation for a follow‑on project combining applied mycology, waste reduction, and regenerative horticulture at Coed Talylan.



